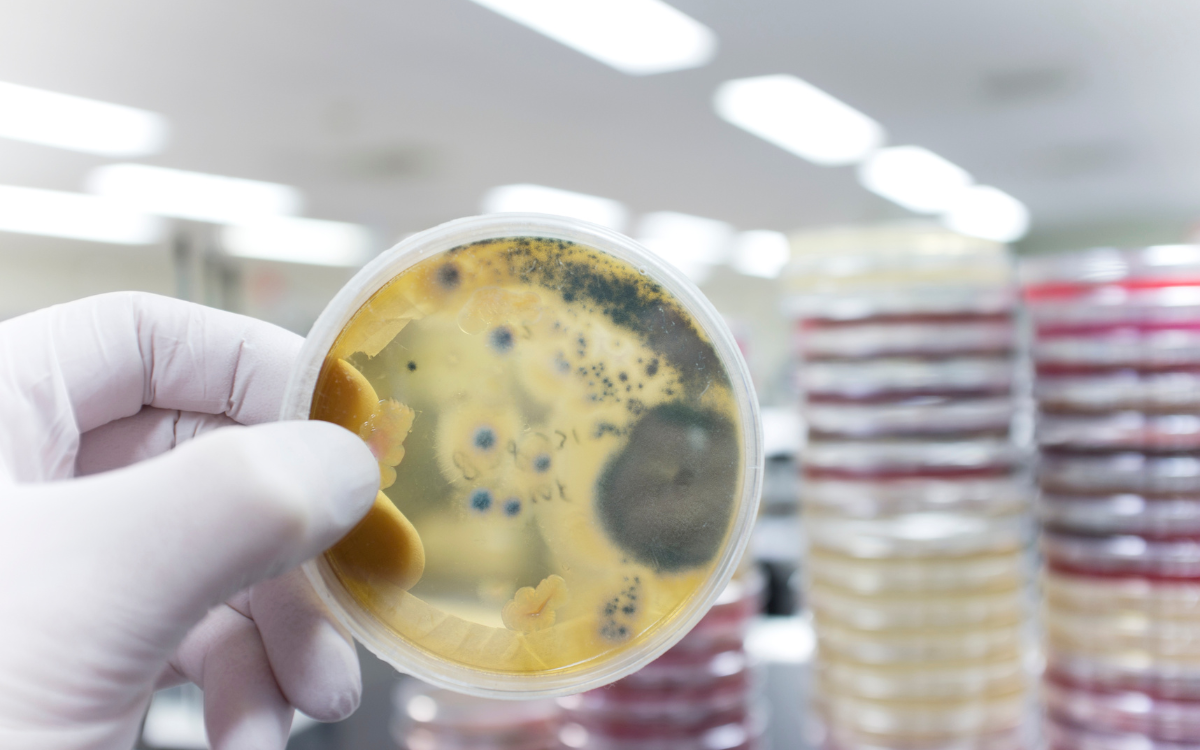
Descubren-un-hongo-capaz-de-descomponer-plastico-en-140-dias

Descubren hongo que descompone plástico y podría salvar el planeta
Medio Ambiente 08/07/2025
Un grupo de científicos descubrió un hongo capaz de descomponer plástico más rápido de lo que jamás imaginamos. Se llama Aspergillus tubingensis y fue hallado en un vertedero en Pakistán. Este champiñón puede descomponer poliuretano, un tipo de plástico común, en cuestión de semanas, algo que normalmente tarda siglos en degradarse.
Pero no es el único, ya que otra seta, llamada Pestalotiopsis microspora, encontrada en la selva amazónica, puede sobrevivir alimentándose exclusivamente de plástico, inclusive sin oxígeno. Sí, un organismo natural que puede vivir comiendo lo que contamina nuestros océanos y ríos.
Aunque aún falta mucho para que estos descubrimientos se apliquen a gran escala, los científicos creen que los hongos podrían ser parte de una nueva generación de tecnología ambiental. La naturaleza ha demostrado que ella misma puede dar soluciones siempre y cuando la escuchamos.


SENPA y Medio Ambiente realizan operativos contra delitos ambientales

Misión científica en Svalbard encuentra tundra y flores donde debía haber nieve


